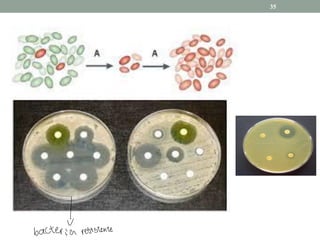
35
|
bacteria resistente

El documento aborda los conceptos generales de antibióticos, su clasificación y propiedades deseables para un buen antibiótico, incluyendo su mecanismo de acción y la resistencia bacteriana. Se discuten las diferencias entre antibióticos bactericidas y bacteriostáticos, así como la importancia de realizar cultivos y antibiogramas para determinar la susceptibilidad de las bacterias. Además, se presentan estrategias para disminuir la resistencia a los antimicrobianos mediante el uso controlado de antibióticos y mejoras en la higiene clínica.